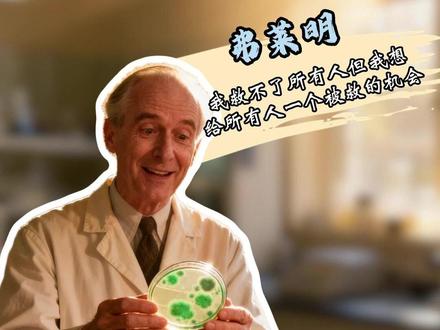
如果这个世界真的有“救世主”——
他可能不穿圣袍,不骑白马。
他只是个穿白大褂的苏格兰老头,
在培养皿前,守了十年,等了一刻。
“他给了我们对抗死神的武器。
但能不能用好它,决定权在我们手上。”
#亚历山大弗莱明 #青霉素 #抗生素 #科学 #英雄

粉丝371获赞318

跟大家分享宝藏博主们,抖音神秘净化组织依旧是写体字, id 依旧透明,小球依旧外网素材搬运工依旧冰岛挪威大吸地依旧卡点变速,剪辑依旧超高锐化画面依旧收图加微依旧全体共用素材。 这种令人作呕的行为正在以病毒式传播。各个 ip 的 人们争先恐后地加入这个所谓的净化组织,混进这个所谓的圈子,就有可能获得与粉丝多的小球共创的机会。我了解这个圈子的原因,是因为我有一个互关之前已经新包装的富二代留学生人设, 发的全是纽约、伦敦、冰岛生活实况。直到有一天,他换上了这个小球的头像。更有甚者,使用 vpn 修改 ip 地址,包装虚假人设进行诈骗。我认为这是非常严重的乱象。然而平台不管不问,竟然给其中几个小球作者的视频选入抖音精选,让真正用心创作的我们无言以对,身心俱疲。

他凭一己之力救了两亿人,如果他当年申请专利,那今天的世界首富绝不会是马斯克。可这位救世主离世时,银行账户里只有三十七英镑。回到一百年前,人类在细菌这个看不见的敌人面前, 脆弱的连蚂蚁都不如。一根生锈钉子,一次拔牙,甚至膝盖擦破点皮,都可能让你在三天内高烧溃烂,哀嚎着死去。而终结这场持续几千年细菌暴症的,正是弗莱明,他从死神手里抢回了至少两亿条命。 这位救世主拿的却是地狱级人参剧本。一八八一年,他出生在苏格兰最荒凉的农场,家里穷到连煤油灯都省着点。 七岁那年,父亲的突然离世,让这个家彻底天塌了,孤儿寡母在风雨里艰难求生。十几岁,他背井离乡去了伦敦,投奔同样贫穷的哥哥。没钱读书,他只能在航运公司当办事员,每天填表格搬货,还要忍受责骂。 这样的日子一熬就是四年。如果命运没转折,他这辈子大概就是个默默无闻的退休职员。但老天给了他一线生机。一位远房叔叔去世,留给他二百五十英镑遗产,他颤抖着用这笔钱敲开了圣玛丽医院医学院的大门。或许是自己淋过太多雨, 他后来才拼了命想给全人类撑伞。一九一四年,一战爆发,年轻的弗莱明作为军医被派往法国前线,那里远比战场残酷。 他每天看着年轻士兵被抬进来,没死于炮火,却死于伤口感染引发的气性坏疽,伤口发黑流脓,恶臭冲天,士兵们在剧痛中抽搐、尖叫,直到断气。医生们只能用碘酒冲洗伤口,可那不仅杀不死深层细菌,反而破坏白细胞, 加速死亡。弗莱明在日记里写道,我站在血泊中,手里握着刀,却救不了任何人。那一刻,他发誓,若能活着回去, 一定要找到一种能精准杀死细菌,却不伤害人体的杀菌子弹。带着这个誓言,他回到伦敦,把自己关进实验室,像个疯子一样寻找他的实验室。邋遢到出名,试管堆成山,培阳敏满地都是。 同事经常嘲笑他的实验室比垃圾场还乱。可恰好是这份乱,撞上了人类史上最不可思议的巧合。 一九二八年九月三日,他度假回来,准备清理一堆忘了洗的培养敏。突然,他的手停住了,一个培养敏里长了一团绿色霉菌, 而霉菌周围致命的葡萄酒菌竟然全部死亡,形成了一圈干净透明的死亡禁区。那天的伦敦,气温刚好低到让青霉菌生长,楼下的真菌实验室刚好飘来了这株霉菌包子,而他刚好忘了洗培养敏。亿万分之一的概率, 上帝亲手把拯救人类的钥匙塞进了他的掌心。他在笔记上颤抖,写下,这可能就是我在找的子弹。 一九二九年,弗莱明公布了自己的发现,可医学界却一片冷漠。有人嘲讽他,发霉的面包能治病。 弗莱明怕不是疯了。更让他绝望的是,青霉素极不稳定,以当时的技术,根本无法将其提纯成可用于临床的药物。作为一名细菌学家,他没有足够的化学知识和手段,只能眼睁睁看着希望搁浅。这一等就是十年没经费,没支持, 实验室冷的像冰窖,全世界都渐渐遗忘了他,可他始终没有扔掉那株霉菌。在那个狭小房间,他想守护唯一的孩子,每周换营养液, 一代代培育下去。他说,总有一天会有人把它变成药。我必须守住这颗火种。就是这份十年如一日的厮守,守住了人类的未来。 一九三九年,牛津大学的弗洛里和前恩团队找到了他,他们用冷冻干燥法成功提纯了青霉素。一九四一年,青霉素首次用于临床救人成功。这时二战爆发,青霉素成了黄色魔力,比子弹更能救命。数百万盟军士兵因他活下来, 美国药企纷纷找上门。只要申请专利,你就是世界首富。弗莱明却摇摇头,青霉素是自然创造的,我只是发现了它。我不能给自然申请专利。为了让穷人也用得起它,放弃了万亿财富,直到去世,仍然是个两袖清风的苏格兰老头。请记住亚历山大弗莱明, 他一生坎坷,却把全人类的生死扛在肩上。他给了我们对抗死神的武器,但能不能用好他,决定权在我们手上。如果你也为这位沉默的巨人动容,请在心里为他点一盏灯。 愿科学之光永不蒙尘,愿救命之药不被轻慢,愿每一份善意与坚守都能被永远铭记。

嗯, 过往 一场,给你自由。

大家都知道有一种女孩是吸渣体质,渣男收割机,还有一种女孩更可怕,是渣男培养敏,渣男的营养液,什么样的男人到他手里最后都变成渣男,说女孩就,嗯,大概有三个特点吧,他性格上面还有做事啊。第一个特点就是把男人把他的老公当成儿子养, 什么事都替他做啊,男人不会洗衣服,男人干不好的家务,男人就不会做饭,整天什么都得让我做,怎样怎样怎样的。他什么活都干,但是他嘴从来都很碎,就一边抱怨一边什么活都干,只有男人被惯的什么活也不干。 然后呢?他他天天抱怨的,也不听他的,就是左耳进右耳出了。第二个特点,他非常自我感动,就像那个电视剧里面苦情女主角一样,悲情人设,很话抱怨的话说尽了, 家里有什么事解决不了他,第一想法不是我出一个解决方案,好,我去一边做这个事,比如说今天把这个东西怎么给他切好,好男主人切多少刀,女主人切多少刀,小孩切多少刀,一起完成。他不, 他首先说啊,你们谁也不干,没有人帮我这个是这活只有我自己干,然后牵到手了,也没有人心疼我,到处哭诉,没有我你们都得饿死,然后还不知感恩,整天这个家只有我去付出。就是 他把所有的活都干了,但是他又把自己立了一个非常苦悲苦的一个境界,然后试图用自己的劳累 去换取大家对他的认可,他的潜意识这样刀子嘴豆心,嗯啊,非常可怕。他他第三点性格就是他对外界的看法,就像裹小脑了一样,就是裹脚步的, 大家都知道吧,裹脚布把脚给解放了,他的脑子被缠住了,就是外界比如说他的邻里邻居的来跟他说啊,你家要没有你可不行啊,你,你太善良了,你,你家你家,你老公这样,你都不跟他离婚,你都跟他过。 这个时候他虽然嘴上抱怨,哎呀,没有人感恩,没有人管我,没有人心疼我怎么怎么样,但是他内心有一种成就感啊,别人夸他一句善良或者怎么样一句,他内心非常的满足, 所以就是他这种情况下,潜意识这种情况下,和他的所作所为。就什么样的男人到他手里都被他培养成渣男,你信不信他的老公被他培养成一个巨婴,什么活都不会干。他如果生儿子,那更惨了, 他儿子从小在这种环境下长大,四肢不勤,五谷不分,又懒惰又懦弱,他以后要娶个儿媳妇,儿媳妇更惨,他儿子要是让他儿媳妇跟他一起干活, 解决问题,改变这种家庭模式,让他儿子成长,他还不愿意呢,觉得他儿媳妇应该跟他一样,也变成悲情女主角,什么活都干,然后把他儿子照顾的像他老公一样,像一个废物一样,就这样的女孩,他自己又悲惨又苦,然后呢?他的老公儿子,家人都被他给养废, 就你说他是好人吗?他肯定不是坏人,但是你说他对这个家族有什么贡献吗?长久以来你觉得是一个良性发展吗?不是,就是如果有女孩是这样的,一定要改变,如果自己妈妈是这样, 一定不要跟他学,如果是婆婆这样,赶紧跑,赶紧跑,要嫁这样的儿子,你知道吗?苦命的开始。